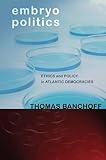
Amazon cover image

Embryo Politics : Ethics and Policy in Atlantic Democracies Banchoff, Thomas
Material type: TextPublication details: Cornell University Press; 2011Description: On-campus e-Book by ebrary under Digital Library Program of Higher Education Commission (HEC) of PakistanISBN:
TextPublication details: Cornell University Press; 2011Description: On-campus e-Book by ebrary under Digital Library Program of Higher Education Commission (HEC) of PakistanISBN: - 9780801460593
| Item type | Current library | Call number | Status | Date due | Barcode |
|---|---|---|---|---|---|
 e-Book
e-Book
|
ICCBS Digital Library | Not for loan |